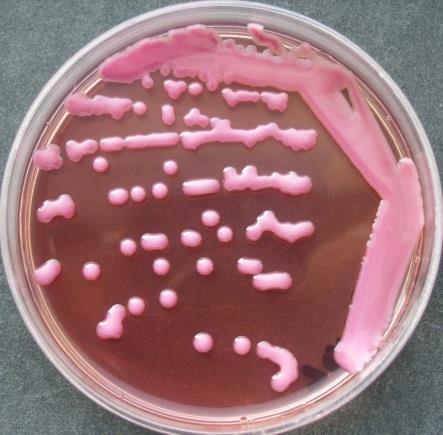
肺炎克雷伯菌在麦康凯培养基上培养24小时
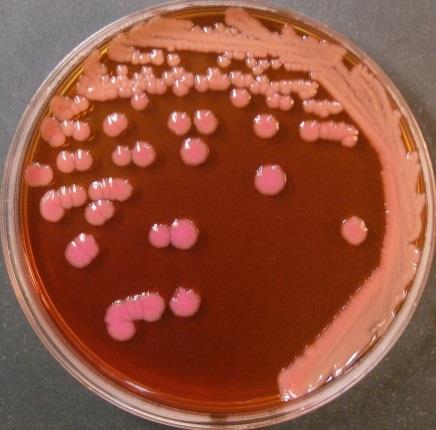
肺炎克雷伯菌在麦康凯培养基上培养48小时
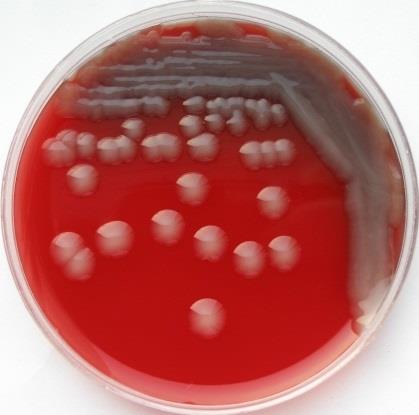
肺炎克雷伯菌在血平板上培养24小时
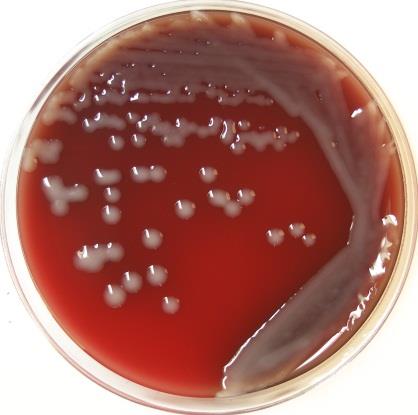
肺炎克雷伯菌在血平板上培养48小时
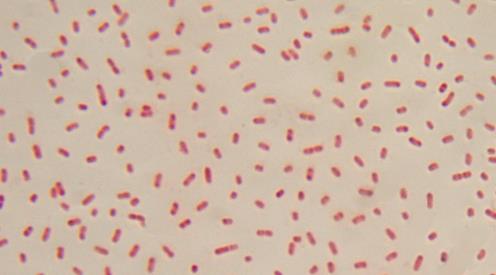
图6 肺炎克雷伯菌的镜下形态特征（革兰染色×1000）

海博微信公众号
海博微信公众号
 海博天猫旗舰店
海博天猫旗舰店


 海博微信公众号
海博微信公众号
 海博天猫旗舰店
海博天猫旗舰店




1 方法来源
ChinaPIN-2022-TZFX019《国家致病菌识别网技术手册肺炎克雷伯菌》
2 适用范围
本程序规定了食品中肺炎克雷伯菌(Klebsiella pneumoniae)的检验方法。
3 培养基和试剂
3.1 磷酸盐缓冲液(PBS)点击查看
3.2 麦康凯培养基 点击查看
3.3 血平板 点击查看
第一法 定性检验
4 检验程序
肺炎克雷伯菌检验程序见图1。

图1 肺炎克雷伯菌检验程序
5 操作步骤
5.1 增菌
以无菌操作取样品25g(mL)加入到含有225mL PBS缓冲液 的均质袋中,在拍击式均质器上连续均质1min~2min;或放入盛有225mL PBS缓冲液的均质杯中,8000r/min~10000r/min均质1min~2min。于36℃±1℃培养8h~18h。
5.2 分离
取PBS增菌液划线接种于麦康凯平板上,于36℃±1℃培养24h~48h,观察各个平板上生长的菌落。肺炎克雷伯菌在麦康凯培养基上形成淡粉色菌落,大而隆起,光滑湿润,呈粘液状(图2),48小时候相邻菌落易融和成脓汁样(图3)。
|
|
|
图2 肺炎克雷伯菌在麦康凯培养基上培养24小时 |
图3 肺炎克雷伯菌在麦康凯培养基上培养48小时 |
自麦康凯平板上分别挑取3个~5个典型或可疑菌落,分别接种在血平板上纯化,于36℃±1℃培养24h~48h。肺炎克雷伯菌在血平板形成白色或略透明大菌落(图4),48h后易融合成片,形成胶水样菌苔(图5),不溶血,无特殊气味产生。
|
|
|
图4 肺炎克雷伯菌在血平板上培养24小时 |
图5 肺炎克雷伯菌在血平板上培养48小时 |
肺炎克雷伯菌经革兰氏染色后在镜下呈现较短粗的革兰氏阴性杆菌,单独、成双或短链状排列,大小约为0.3μm~1.5μm×0.6μm~6μm。无芽胞,无鞭毛(图6)。
图6 肺炎克雷伯菌的镜下形态特征(革兰染色×1000)
5.5 鉴定
5.5.1 生化鉴定:常见的微生物生化鉴定系统,如VITEK 2(用GN卡)、BD-Phoenix100生化仪、生物梅里埃公司生产的API生化鉴定试剂条等均可鉴定肺炎克雷伯菌。
5.5.2 微生物质谱鉴定:目前常见的微生物质谱仪均能很好地鉴定肺炎克雷伯菌。
相关产品:
上一篇:动物胴体的采样计划与要求
下一篇:嗜热菌标准操作程序



